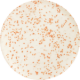
Daphnies (Daphnia Pulex) 180ml - Nourriture vivante

Aucun produit
Nourriture Vivante pour Aquarium
-
Matériel d'Aquascaping
- Outils de Plantation
- Hardscape : Roches et Racines
- Colles & Supports pour plantes et mousses d’aquarium
- Verrerie CO2 & accessoires en verre pour aquarium
-
Produits ADA (Aqua Design Amano) – Aquascaping haut de gamme
- Aquariums ADA Cube Garden
- Engrais & Fertilisation ADA
- Conditionneurs & Traitement de l’Eau ADA
- Sables & Graviers ADA
- Substrats & Sols Nutritifs ADA
- Additifs pour Sols ADA
- Verrerie ADA – Lily Pipes, Diffuseurs CO₂ & Accessoires
- Eclairage ADA
- Accessoires ADA
- Systèmes CO2 ADA
- Filtration ADA
- Goodies & Produits dérivés ADA
- Outils ADA
- Gamme Aquaplante – meilleur rapport qualité/prix
- Univers Chihiros – Rampes & système aquarium
- Univers DOOA by ADA : aquariums, accessoires & systèmes plantés
- Gamme Dupla
- Gamme Easy-Life
- Gamme Tropica
- Gamme Twinstar
- Yokuchi – Sols & Engrais Premium
- VIV – Verrerie premium pour aquarium planté
-
Plantes Aquatiques
-
Plantes d'aquarium
- Toutes les plantes aquatiques
- Bucephalandra
- Mousses pour aquarium
- Lots de plantes d'aquarium
- Plantes d'aquarium Gazonnantes
- Avant plan d'aquarium
- Milieu Plan d'aquarium
- Arrière plan d'aquarium
- Plantes d'aquarium flottantes
- Plantes d'aquarium colorées
- Plantes à bulbe et autres formes
- Résistantes aux phytophages
- Plantes d'aquarium ECO
- Plantes d'aquarium STANDARD
- Plantes d'aquarium PREMIUM
- Plantes d'aquarium IN VITRO
- Pied mère
- Plantes d'aquarium SUR SUPPORT
- Plantes sur tapis / grillage
- Biotope Amazonien - Américain
- Biotope Asiatique
- Biotope Africain
- Plantes à croissance rapide (concurrence des algues)
- Outils de Plantation
- Engrais & fertilisants d'aquarium
- Substrats, Sols nutritifs & Sables
-
Plantes d'aquarium
-
Décorations d’aquarium : fonds, roches, racines & thèmes
- Fonds d’aquarium 3D & posters décoratifs
- Décoration naturelle
- Amphores décoratives pour aquarium
- Figurines & décors animaux pour aquarium
- Châteaux & Forteresses décoratives pour aquarium
- Décors marins : coraux & coquillages pour aquarium
-
Décors d’aquarium civilisations & temples
- Décors anglais pour aquarium
- Décors d’aquarium Grecs : colonnes & temples
- Décors égyptiens pour aquarium (pyramides, sphinx & pharaons)
- Décors romains pour aquarium : temples & colonnes antiques
- Décors aztèques pour aquarium : temples & statues mayas
- Décors asiatiques pour aquarium : temples, dragons & bonsaïs
- Décors Hawaïens et Tiki pour aquarium
- Décors USA & Western pour aquarium
- Décors africains d’aquarium – cases, huttes & statues
- Épaves & Bateaux coulés pour aquarium
- Décors d’aquarium Espace & Extraterrestres
- Décors Monstres & Fantaisie pour Aquarium
- Décorations flottantes pour aquarium
- Décors fluorescents & UV réactifs pour aquarium
- Décors thème mer pour aquarium
- Décors crânes & fossiles pour aquarium
- Grottes, cachettes et maisons d’aquarium
- Décors lumineux & spots LED submersibles
- Décors militaires pour aquarium
- Décors Plage & Bord de mer pour aquarium
- Décors d’aquarium pour enfants
- Terrasses & parois rocheuses pour aquarium
- Racines artificielles pour aquarium (décors réalistes)
- Roches artificielles pour aquarium (décors pierre)
- Statues & décors zen pour aquarium
- Perles de verre décoratives pour aquarium
- Plantes artificielles pour aquarium
-
Aquariums
- Cuve Nue
- Meubles pour aquarium
- Cuve Nue Verre Extra Blanc
- Aquarium Boule
- Aquarium Plastique
- Aquarium Nano
- Aquariums Betta
- Aquariums AquaEl
- Aquariums AQUARIUM SYSTEMS
- Aquariums BiOrb
- Aquariums BLUE MARINE
- Aquariums ADA
- Aquarium Dupla
- Aquariums EHEIM
-
Aquariums JUWEL
- Gamme d'Aquariums Juwel Lido
- Gamme d'Aquariums Juwel Primo
- Gamme d'Aquariums Juwel Rio
- Gamme d'Aquariums Juwel Trigon
- Gamme d'Aquariums Juwel Vision
- Accessoires pour Aquarium Juwel
- Décoration pour Aquarium Juwel
- Eclairage pour Aquarium Juwel
- Médias de Filtration pour Aquarium Juwel
- Pièces détachées pour Aquarium Juwel
- Aquariums OASE
- Aquariums SUPERFISH
- AQUARIUM SERA
- Aquariums River Aqua
- Aquariums WAVE
- Aquariums Red Sea
- Aquariums VIV
- Aquariums River Aqua
- Aquariums Tetra
- Aquarium MAXSPECT
- Aquariums AQUAMEDIC
-
Matériel
-
Accessoires Aquarium
- Nettoyeurs de vitres & aimants
- Aspirateurs de fond & siphons
- Bouturage coraux
- Seringues & accessoires
- Changement d’eau aquarium
- Colles & silicone
- Couvercles & filets anti-saut
- Distributeurs automatiques
- Électricité aquarium
- Elevage des artémias
- Epuisette pour Aquarium
- Désinfection - Sanitaire
- Goupillons pour Aquarium
- Pièges à Poissons / Escargots
- Pièges à vers
- Pinces et Ciseaux pour Aquarium
- Pondoirs et supports de ponte
- Réductions, Coudes et Manchons
- Robinets et Vannes d'arrêt
- Tapis pour aquarium
- Thermomètres et Densimètres pour Aquarium
- Tuyauterie
- Ventouses pour Aquarium
- Emballage / Transport
- Librairie
- Aération
- Gestion de la Température
- Systèmes CO2 d'aquarium
-
Eclairage d'aquarium
- Rampes et Galeries d'Eclairage
- Eclairage pour Nano-Aquariums
- Spots LED Submersibles
- Ampoules et Tubes d'éclairage
- Accessoires
-
Filtration d'aquarium
- Décantation
- Filtre Cascade
- Filtre Interne
- Filtre Externe
- Skimmer de surface
- Filtre Exhausteur
- Masses de Filtration
- Recharges pour filtres
- Stérilisateurs UV
- Accessoires de filtration
- Osmoseurs
- Pompes à eau
-
Pièces Détachées
- Aqua Design Amano
- AquaForest
-
Aquarium Systems
- Aquarium Systems - NewJet
- Aquarium Systems - Newave
- Aquarium Systems - Vento
- Aquarium Systems - Série 6
- Aquarium Systems - Maxijet MJ
- Aquarium Systems - Aspirateur PGC
- Aquarium Systems - Maxi-Jet Wave
- Aquarium Systems - VisiTherm Mini (Chauffage)
- Aquarium Systems - Maxi-Jet Micro
- Aquarium Systems - New Jet Filter
- Aquarium Systems - VisiTherm (Chauffage)
-
Blue Marine
- Blue Marine - Aquariums Reef 60 / 125 / 200 / 350
- Blue Marine - Algae Reactor
- Blue Marine - A.T.O
- Blue Marine - Calcium Reactor
- Blue Marine - Chiller
- Blue Marine - DC Power
- Blue Marine - Dosing Pump
- Blue Marine - ReefPower
- Blue Marine - Skimmer
- Blue Marine - WIFI Max LED
- Blue Marine - Nano LED
- Blue Marine - UFO LED
- Colombo
- Eden
-
EHEIM
- Eheim - Filtres Internes - PowerLine
- Eheim - Filtres Internes - Biopower
- Eheim - Filtres Externes - 2260 Classic 1500 XL
- Eheim - Classic
- EHEIM - Compact
- EHEIM - MiniFLAT
- EHEIM - MiniUP
- EHEIM - Skim 350
- EHEIM - Eccopro
- EHEIM - Professionnel
- EHEIM - Universal
- EHEIM - Quick Vac (Aspirateur)
- EHEIM - Ecco
- EHEIM - Pick Up
- Horizon Aqua
- JBL
- Newa
-
OASE
- OASE - Aqua In-Out Set 800
- OASE - Aquarium HighLine
- OASE - Aquarium StyLine 85
- OASE - Aquarium StyLine 125
- OASE - BioCompact
- OASE - Biomaster
- OASE - BioPlus
- OASE - ClearTronic
- OASE - FiltoSmart
- OASE - FishGuard
- OASE - HeatUp
- OASE - HeatUp Basis
- OASE - OxyMax
- OASE - OptiMax
- OASE - StreamMax
- Oase - FiltoMatic
- OSRAM
- Juwel - Pièces détachées Aquarium
- Seachem
- Schego
-
SERA
- SERA - Filtre Externe UVC-Xtreme
- Sera - Filtre Externe Bioactive
- Sera - Filtre Interne Sera Fil
- Sera - Pompe / Filtre Série F / P
- Sera - Systèmes UV-C
- SERA - AQUARIUM BIOTOP NANO
- SERA - AQUARIUM BIOTOP CUBE
- Sera - Pompe à Air
- Sera - Feed A Plus
- Sera - Aquarium Marin Biotop
- Sera - Marin Protein Skimmer
- Sera - LED Chip
- Sera - Biotop Nano Led Cube
- Sera - Reacteur CO2 Sera Flore 500/1000
- Sera - Pompe Marin stream pump SPM
- Sera - Pompe à eau FP
-
SICCE
- SICCE - Chauffages JOLLY
- SICCE - Chauffages SCUBA
- SICCE - FILTRES ECOMAX
- SICCE - FILTRES ECOPOND
- SICCE - Filtres GREEN RESET
- SICCE - FILTRES NANOMICRON / MICRON
- SICCE - Filtres SPACE EKO+
- SICCE - Filtres WHALE
- SICCE - POMPES AQUA 3
- SICCE - POMPES EASY LINE
- SICCE - POMPES EKO POWER
- SICCE - POMPES MASTER DW
- SICCE - POMPES MULTI
- SICCE - POMPE ULTRA ZERO
- SICCE - POMPES SYNCRA ADV
- SICCE - POMPES SYNCRA HF
- SICCE - POMPE SYNCRA NANO
- SICCE - POMPES SYNCRAPOND
- SICCE - POMPES SYNCRA SDC WIFI
- SICCE - POMPES SYNCRA SILENT
- SICCE - POMPES VOYAGER NANO
- SICCE - POMPE XSTREAM / XSTREAM e / XSTREAM SDC
-
Superfish
- Superfish - Aqua 20 / 30 / 40 / 45 / 60
- Superfish - Air Flow
- Superfish - AquaFlow
- Superfish - Aquaponics 10 / 23
- Superfish - AquaPower / PondPower
- Superfish - Cascade 4 / 10
- Superfish - Corner Filter
- Superfish - Filtres Externes Eco Flow
- Superfish - Filtres Externes X PRO
- Superfish - Hang on
- Superfish - Home 8 / 15 / 25 / 30 / 40 / 45 / 60 / 65 / 85 / 110
- Superfish - Quadro
- Superfish - Qubiq 30 / 60
- Superfish - Panorama 20 / 35 / 50
- Superfish - Retro LED
- Superfish - Scaper
- Superfish - Scaper Qube
- Superfish - Slim LED / Multi LED Stick
- Superfish - Smart Heater
- Superfish - Surface Skimmer
- Superfish - Surface Skimmer 300
- Superfish - Scaper LED
- Superfish - Start 20 / 30 / 50
- Tetra
- Tunze
- VIV
- SECOH
- Red Sea
- Verrerie : Matériel Aquarium
- Automatisation
- Goodies
- Chèques Cadeaux
-
Accessoires Aquarium
-
Nourriture
- Nourriture Congelée
- Nourriture Vivante
- Nourriture Betta
-
Nourriture Sèche
- Nourriture Sèche Pour Axolotls
- Nourriture Sèche Pour Alevins
- Nourriture Sèche Pour Betta
- Nourriture Sèche Pour Cichlidés
- Nourriture Sèche Pour Crevettes et Crabes
- Nourriture pour Coraux
- Nourriture Sèche Pour Discus
- Nourriture Sèche Pour Escargots
- Nourriture pour FlowerHorn / Red Parrot
- Nourriture Sèche Pour Guppy
- Nourriture Sèche Pour Poissons d'Eau Froide
- Nourriture Sèche Pour Poissons Marins
- Nourriture pour Prédateurs (Arowanas, Raies...)
- Nourriture Sèche Pour Loricaridés (Pléco, baryancistrus...)
- Nourriture Sèche Pour Nanos Aquariums
- Nourriture Sèche Pour Poissons de Fond
- Nourriture Sèche Pour Poissons Tropicaux
- Nourriture Sèche Pour Tortue
- Nourriture Sèche Pour Poissons Végétariens
- Nourriture Sèche Pour les Vacances
- Nourriture Vrac
-
Nourriture par marque
- Nourriture AquaForest
- Nourriture AQUARIUM SYSTEMS pour poissons
- Nourriture BENIBACHI pour crevettes
- Nourriture DR BASSLER pour poissons
- Nourriture DUPLA pour poissons
- Nourriture HIKARI pour poissons
- Nourriture JBL pour poissons
- Nourriture OASE pour poissons
- Nourriture RIVER AQUA pour poissons
- Nourriture SERA pour poissons
- Nourriture TETRA pour poissons
- Nourriture TROPICAL pour poissons
- Nourriture liquide
-
Soins & Traitements
- Soins des plantes
-
Soins des poissons
- Soins Anti-Stress pour poissons
- Soins pour poissons contre la maladie des trous
- Soins pour poissons contre la maladie du velours
- Soins pour poissons contre les mycoses
- Soins pour poissons contre les points blancs
- Soins pour poissons contre les vers
- Soins pour poissons contre les infections bactériennes
- Soins pour poissons contre la pourriture des nageoires
- Soins pour poissons contre tous parasites
- Vitamines et Minéraux pour poissons
- Traitement de l'eau
- Soins Naturels
- Analyse de l'eau
-
Matériel de Bassin
- Plantes de bassin
- Accessoires
- Aération de bassin
- Anti-Nuisibles
- Chauffage / Anti Glace
- Construction
- Décoration
- Filtration de bassin
- Nourriture
- Pompes à eau de bassin
- Soin des plantes
- Soin des poissons
- Stérilisation - UVC
- Traitement de l'eau
-
Pièces Détachées
-
Oase
- Oase - AquaMax Dry
- Oase - Bitron Eco
- Oase - AquaMax Eco Classic
- Oase - AquaMax Eco Expert
- Oase - AquaAir 250
- Oase - AquaMax Eco Premium
- Oase - Air Flow
- Oase - Bitron
- Oase - Aqua Oxy
- Oase - AquaMax Eco Titanium
- Oase - AquaMax Eco Twin
- Oase - Aquamax Gravity Eco
- Oase - Aquarius Eco Expert
- Oase - Aquarius Fountain Set
- Oase - Aquarius Solar
- Oase - Skimmer
- Oase - Biopress Set
- Oase - Aquarius Universal
- Oase - BioSmart
- Oase - Aquarius Universal Premium
- Oase - BioSys Skimmer
- Oase - Biotec
- Oase - BioTec Screenmatic²
- Oase - Bitron C
- Oase - PondoVac
- Oase - Filtomatic
- OASE - Bitron Gravity
- Oase - FiltoClear
- Oase - Filtral UVC
- Oase - IceFree
- Oase - Oxy Tex
- Oase - InScenio
- Oase - Jumping Jet Rainbow
- Oase - lame d'eau
- Oase - Volcan
- Oase - Water
- Oase - Vitronic
- Oase - PONDJET ECO
- Oase - LunAqua Power LED
- Oase - Eco expert control
- Oase - SwimSkim
- Oase - aspirateur Pondovac
- Oase - Lunaqua Classic LED
- Oase - ProfiClear Premium
- Oase - ProfiLux
- Oase - LunAqua
- Oase - Profiguard
- Oase - FP
- Oase - Water Jet Lightning
- Oase - BioTec Premium
- Oase-ProfiClear Premium Compact
- Oase-ProfiSkim
-
Pontec
- Pontec - PondoVario
- Pontec - Pondoair
- Pontec - PondoSolar
- Pontec - PondoCompact
- Pontec - Ponduett
- Pontec - Pondorell
- Pontec - PondoCompact
- Pontec - Pondomax
- Pontec - Pondoclear
- Pontec - Multiclear
- Pontec - Pondopress
- Pontec - PondoClear
- Pontec - PondoPolar
- Pontec - Pondomatic
- Pontec - PondoSkim
- Pontec - PondoFog
- Koi Pro
- Secoh
- SERA
- Superfish
-
Oase
- L'art du Terrarium / Paludarium
- Wabi-Kusa / Kokedama
-
Promotions & Fins de série
- Terrariophilie
- Eau douce
- eau de mer
- bassin
- PROMOS Plantes Aquarium
- Chauffages en promotion
- ADA
- AQUAFOREST
- AQUANOVA
- AQUAPLANTE
- AQUARIUM SYSTEMS
- ARCADIA
- BLUE MARINE
- CERAMIC NATURE
- COLOMBO
- DOOA
- DUPLA
- EDEN
- EHEIM
- EUROPET
- GROTECH
- HOBBY
- HORIZON AQUA
- JBL
- JUWEL
- NEWA
- OASE
- PONTEC
- PREIS
- RED SEA
- RICORDEA FARM
- SYLVANIA
- SAVIC
- SEACHEM
- SERA
- SICCE
- SUPERFISH
- TETRA
- TUNZE
- TWINSTAR
- VIV
- WAVE
- ZOLUX
- ZOOMED
-
Eau de Mer
- Accessoires
- Filtration
- Ecumeurs
- Traitement de l'eau et des coraux
- Substrat pour aquarium marin
- Eclairage Marin
- Réacteurs
-
Gamme AquaForest
- Aquariums AquaForest
- Colles AquaForest
- Décantations AquaForest
- Elements Trace AquaForest
- Filet & Chaussette AquaForest
- Médias de Filtration AquaForest
- Nourriture Coraux AquaForest
- Nourriture Poisson AquaForest
- Probiotiques & Nitrification AquaForest
- Roches & Plugs AquaForest
- Sels AquaForest
- Silicone & Lubrifiant AquaForest
- Skimmers et réacteurs AquaForest
- Soins des coraux AquaForest
- Soins des poissons AquaForest
- Substrats AquaForest
- Tests d'eau AquaForest
- Tuyauterie & ByPass AquaForest
- Traitements de l'eau AquaForest
- Gamme Horizon Aqua
- Gamme Red Sea
- Roches Artificielles Eau de Mer
- Gamme Salifert
- Gamme AQUA MEDIC
- Terrariophilie et Oisellerie
-
Poissons & Invertébrés
- Invertébrés d'eau douce
- Invertébrés terrestres
- Poissons d'eau douce
- Carpes Koï
- Autres Poissons de bassin
- Algues marines
-
Poissons Marins
- Anthias (Serranidés)
- Apogons (Apogonidés)
- Balistes (Balistidés)
- Blennies (Blenniidés)
- Carangues
- Demoiselles (Pomacentridés)
- Gobies (Gobiidés)
- Hippocampes (Syngnathidés)
- Labres (Labridés)
- Lutjans (Haemulides)
- Merous et Pseudochromis (serranidés)
- Murenes (Muraenidés)
- Poissons Anges (Pomacanthidés)
- Poissons Chauve-Souris (Ephippidés)
- Poissons Chirurgiens (Acanthuridés)
- Poissons Clowns (Pomacentridés)
- Poissons Coffres (Ostraciidés)
- Poissons Limes (Monacanthidae)
- Poisson-mandarin (Synchiropus)
- Poissons Papillons (Chaetodonidés)
- Poissons Perroquets (Scaridae)
- Siganus (Siganidés)
- Poissons faucons (Cirrhitidés)
- Malacanthidae
- Raretés - Inclassables
- Coraux et Invertébrés marins
- Pierres vivantes
- Paludariums / Insectariums
- Aménagement du jardin
Recherche dans le blog
Derniers articles
Comment bien utiliser rampe LED récifale sans erreur?
Comment éviter les algues dans un aquarium d’eau douce
Hardscape pour aquarium : comment bien choisir les roches et les racines
Algues en aquarium d’eau douce : causes, prévention et solutions
Découvrez notre Top 10 : filtres externes pour aquarium à ne pas manquer
Archives du blog
 Agrandir l'image
Agrandir l'image
-
Utilisation en Eau Douce

-
Utilisation en Eau de Mer

Daphnies (Daphnia Pulex) 180ml - Nourriture vivante
La nourriture de base de l'élevage aquariophile par excellence
7380 Produits en stock
En stock chez le producteur : toute commande passée avant le dimanche soir 22 heures sera expédiée le mardi ou le mercredi suivant (sauf particularité de semaines avec jour férié)
En stock
N3030025
Prix dégressifs
| A partir de (qté) | Remise | Vous économisez |
|---|---|---|
| 6 | 6% | Jusqu'à 2,32€ |
| 12 | 10% | Jusqu'à 7,74€ |
| 24 | 15% | Jusqu'à 23,22€ |
| 72 | 20% | Jusqu'à 92,88€ |
Description Daphnies (Daphnia Pulex) 180ml - Nourriture vivante
La daphnie à donné son charme à l'aquariophilie pendant des années, en permettant à de nombreux aquariophiles de partir à la chasse à la nourriture vivante en été pour nourrir leurs poissons.
Aujourd'hui, nous pouvons vous proposer la daphnie en dose, ce qui vous évitera les désagréments des maladies et des autres insectes nuisibles à l'aquarium (larve de libellule par exemple)
Dose de 180ml
Espèces de poissons d'aquarium d'eau douce qui mangent des Daphnies vivantes :
-
Tétras (Néon, Cardinalis, Citron, Sang) → parfaites pour leur taille de bouche.
-
Rasboras (Arlequin, Hengeli, Galaxy) → riches en fibres, stimulent l’appétit.
-
Barbus, Danios, Killies, Poissons arc-en-ciel → proies légères très digestes.
-
Guppy, Platy, Molly, Xipho → friandise naturelle qui stimule la reproduction.
-
Betta splendens → excellent aliment pour varier l’apport en protéines sans graisses.
-
Cichlidés nains (Apistogramma, Ramirezi) → déclencheur naturel de ponte.
-
Corydoras et loches → consomment volontiers les daphnies mortes ou au sol.
Précautions :
-
Les Daphnies vivantes doivent être rincées soigneusement avant distribution (risque de pollution).
-
À donner en quantité modérée : trop riches pour une consommation quotidienne.
-
Évitez les vers de provenance douteuse (eaux polluées)
-
Distribuer 1 à 2 fois par semaine comme friandise ou en phase de reproduction.
Espèces de poissons de bassin qui mangent des Daphnies vivantes :
-
Poissons rouges, Koï, Shubunkin, Comète, Sarasa → nourriture vivante légère et digeste.
-
Très utile au printemps et à l’été, quand le métabolisme augmente.
-
Apporte vitalité et stimule la chasse, sans surcharger le système digestif.
Précautions :
-
À donner en petites quantités, une à deux fois par semaine.
-
Évitez la distribution par temps froid (eau < 12 °C).
-
Préférez des vers d’élevage contrôlé pour éviter tout risque bactérien.
Espèces de poissons marins et invertébrés qui mangent des Daphnies vivantes :
-
Poissons-clowns, gobies, hippocampes, coraux mous → consomment les petites daphnies vivantes comme microplancton nutritif.
-
Alternative légère aux artémias, idéale pour l’acclimatation ou les jeunes poissons.
Conseils :
-
Toujours rincer abondamment à l’eau salée du bac avant distribution.
-
Donner en petite quantité pour éviter la pollution organique.
Avantages nutritionnels :
-
Riches en protéines (≈ 50 %), vitamines et minéraux.
-
Très pauvres en graisses, ce qui évite l’embonpoint ou les troubles digestifs.
-
Stimulent les comportements naturels de chasse et la reproduction.
-
Aident à la régulation du transit intestinal des poissons.
Précautions d’utilisation :
-
Température de stockage : 5 à 15°c
-
Conservation : 1 à 2 semaines en fonction de la température
-
À donner vivantes ou congelées, seules ou en alternance avec artémias ou tubifex.
-
Conserver au frais et aérer légèrement avant distribution.
Liens utiles pour compléter l'alimentation de vos petits protégés :
Pour une alimentation optimale, découvrez également nos gammes de Nourriture vivante et Nourriture congelée et Nourriture sèche.
Toutes les doses de nourriture vivante que nous vous proposons sont garanties vierges de tout parasite et autres maladies par le producteur.
ATTENTION : La nourriture vivante n'est pas garantie avec les modes de transport autres que Express.
Pour des raisons d'approvisionnement, nous nous laissons la possibilité d'échanger les doses de Vers de vase manquantes par les espèces suivantes: Artemias, Larves de Moustiques blanches, California blackworms ou Vers de vase.
Caractéristiques
- Oui
- Oui
-

Emballage de qualité
pour une livraison en toute sécurité